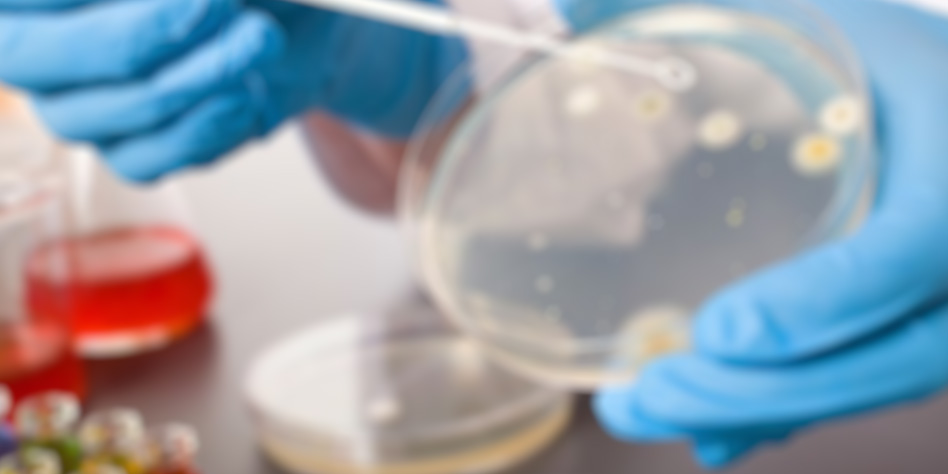
...

Humanet Handset Icon Description
We, as Humanets, have an icon in our handset that includes
My Humanet IDs, Emergency,
Medical, Travel, Laboratory Test, and X-ray.
This will assist you in a variety of ways and save you
time. This phone has your personal information on it.
medical information about your emergency
contact
your past travel experiences your urinalysis and
x-ray results in pdf or picture format This is
especially useful if you require a file at any time or from any location.